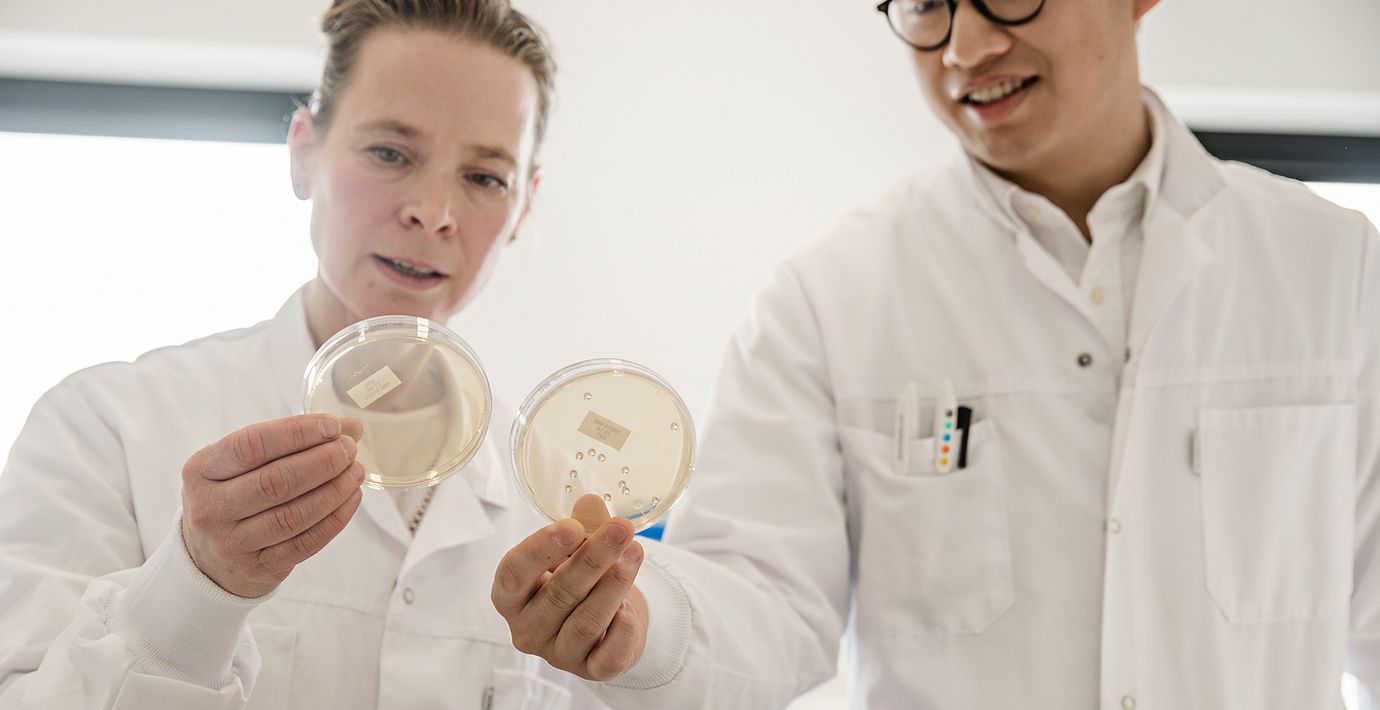

Försäljningen ökade på alla Biogaias marknader
Biogaia ökade rörelseresultatet med 28 procent i det tredje kvartalet, medan omsättningen ökade med 23 procent.
Bakom försäljningslyftet står samtliga geografiska marknader, skriver den nytillträdda vd:n Theresa Agnew. Även direktförsäljningen har gått starkt framförallt i USA och Kanada.
”På de här marknaderna kan vi fokusera mer på våra egna produkter, lansera ett bredare urval av vår produktportfölj och ytterligare stärka varumärket Biogaia”, skriver vd:n.
Tredje kvartalet
Omsättning: 318 mkr
2022: 258 mkr
Rörelseresultat: 120 mkr
2022: 93,7 mkr
Rörelsemarginal: 38%
2022: 36%
Omni är politiskt obundna och oberoende. Vi strävar efter att ge fler perspektiv på nyheterna. Har du frågor eller synpunkter kring vår rapportering? Kontakta redaktionen